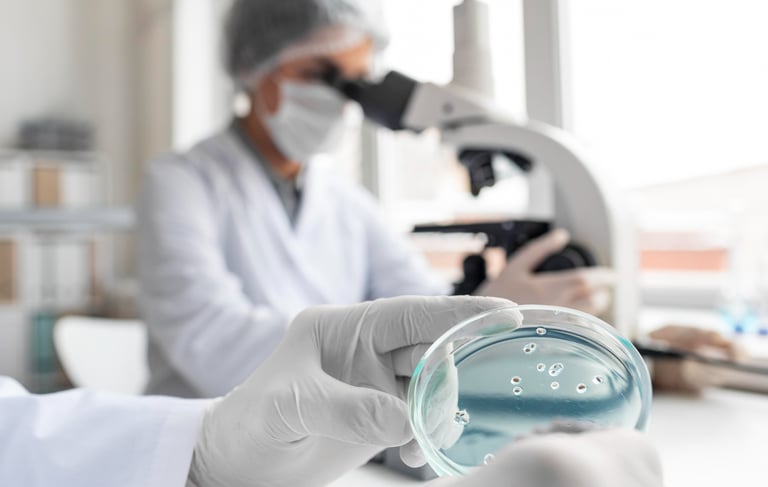
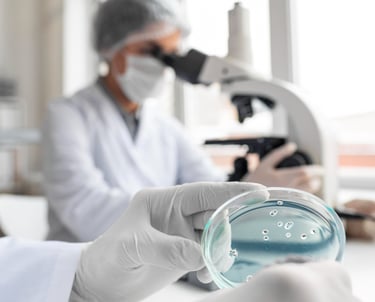

EM BREVE...
Aguarde.
Estamos construindo esta página para disponibilizar consultas a resultados com o melhor serviço em exames laboratoriais. Em breve, em funcionamento.

UNIDADES


SOBRE
Consulte nossas unidades e horários de funcionamento. Clique abaixo:
A StarLabs se consolida como referência em análises clínicas, oferecendo precisão diagnóstica aliada à excelência e tecnologia de ponta.
Com mais de 5 anos de experiência no segmento público e privado, nossos exames são realizados com equipamentos de última geração, garantindo resultados confiáveis e ágeis.
Laboratório StarLabs | Todos os direitos reservados.
